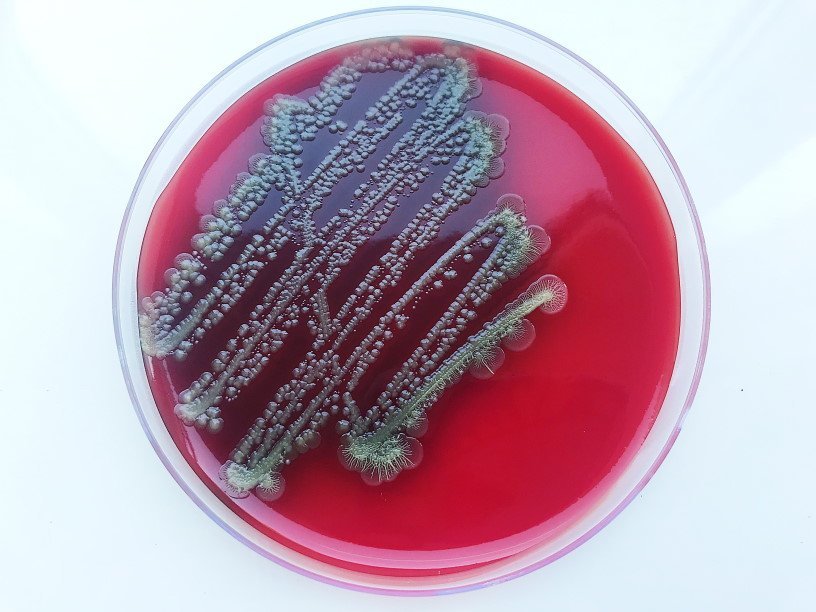

Екатерина Беленко: Промикробы: Скрытая угроза
Фото: Екатерина Беленко Люди часто употребляют это слово в разговоре, но знают ли они, что значит «инфекция»? Давайте попробуем разобраться, хотя это займёт не одну неделю. Инфекция — это заражение живых организмов, а вот чем или кем — тут загибаем пальцы. Бактериями, грибами, простейшими, вирусами, прионами, паразитами, даже членистоногими, как бы страшно это ни звучало. Нас с вами больше всего интересуют бактерии, поэтому о них и поговорим. Кстати, забавный факт — исторически слово «инфекция» впервые было введено для обозначения венерических болезней.
Инфекция — это совокупность всех процессов, возникающих в организме при внедрении и размножении в нем микроорганизмов, это результат взаимоотношений между макро- и микроорганизмом. Инфекция может развиваться в разных направлениях и принимать различные формы. Форма развития инфекции зависит от соотношения патогенности микроорганизма, факторов защиты макроорганизма и факторов окружающей среды.
По длительности инфекционный процесс может быть острым и хроническим. Острая инфекция заканчивается удалением возбудителя или смертью больного. Согласитесь, звучит очень позитивно. При хронической инфекции возбудитель длительно сохраняется в организме (это состояние называется персистенция). В чем тут сложность для маленького агрессора? Надо тем или иным способом остаться незамеченным для караула иммунной системы. Например, можно залезть внутрь клетки макроорганизма и там переждать. А есть ещё более впечатляющий способ: укрыться в том органе, в котором тебя не будут искать, — в головном мозге. Между мозгом и системой кровообращения существует гематоэнцефалический барьер, знали? Он защищает нервную ткань от циркулирующих в крови микроорганизмов, токсинов, а также факторов иммунной системы, которые воспринимают ткань мозга как чужеродную. Вместе с тем наличие гематоэнцефалического барьера затрудняет лечение многих заболеваний центральной нервной системы, так как он не пропускает целый ряд лекарственных препаратов. Другими словами, с точки зрения микроба, если туда проскочить, то ты в швейцарском шоколаде.
По степени распространения инфекционный процесс бывает локальный и генерализованный. Локальная инфекция — местное повреждение тканей организма под действием патогенных факторов вероломно вторгшихся малюток. Локальный процесс, как правило, возникает на месте проникновения микроба в ткани и обычно характеризуется развитием местной воспалительной реакции. Локальные инфекции представлены, например, ангинами и фурункулами. Генерализованная инфекция — та инфекция, при которой возбудители распространились по всему макроорганизму. Существует два основных пути распространения — по лимфе и по крови.
По степени выраженности инфекционные процессы принято делить на манифестные и инаппарантные. Манифестная инфекция — это инфекция с явными специфическими клиническими признаками, ярко выраженная. «Инаппарантный» — это заумный синоним слова «бессимптомный». В таком случае размножение возбудителя в организме сопровождается не клиническими проявлениями, а только иммунными реакциями.
На сегодня всё, продолжение следует. А вы пока разучивайте слова «гематоэнцефалический» и «инаппарантный», особенно если хотите впечатлить парня или девушку-медика.
Смотрите также: Екатерина Беленко Промикробы: Красная и синяя таблетки Екатерина Беленко Промикробы: Волшебная палочка Екатерина Беленко Промикробы: Кровь и пептон Екатерина Беленко Промикробы: С широко открытыми глазами